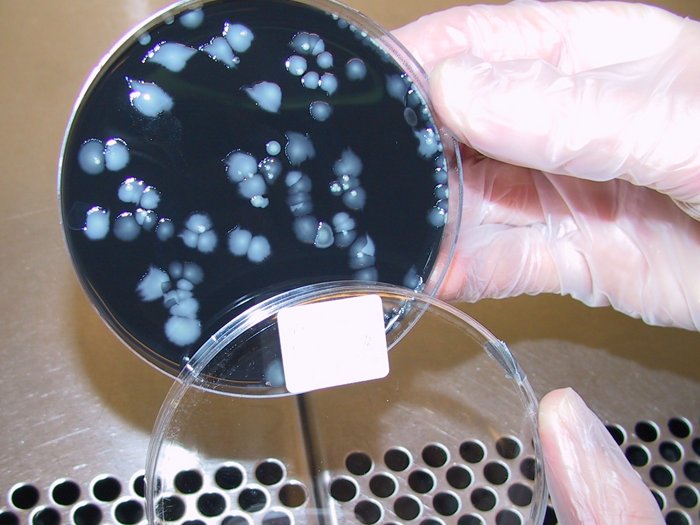

Ekspert sætter spot på kødædende bakterier
THISTED: ”Kødædende bakterier – hvad kan vi lære af de voldsomme patientforløb?” er emnet ved et foredrag, som AOF Aftenskolen i Thisted onsdag aften 6. april arrangerer i Salen, Refsvej 69 i Thisted Bolig.
Ved foredraget kommer tager foredragsholder, læge Marco Bo Hansen, deltagerne med på en rejse gennem bakteriernes verden.
”Vi er omgivet af dem - til lands, til vands og i luften, og de udgør to kg af vores kropsvægt. Nogle bakterier er gavnlige for os, mens andre er skadelige og kan forårsage sygdomme. Foredraget tager udgangspunkt i fortællinger fra patienter med eksempler på, hvor der kan ske fejl i sundhedsvæsenet, og hvad man som borger skal være opmærksom på”, hedder det i omtalen af arrangementet.
Denne aften giver Marco Hansen deltagerne bl.a. råd og guidance til, hvad man selv kan gøre, hvis man står i en lignende situation med fokus på at få den bedst mulige behandling.
Målet er at nedbringe ulighed i sundhed.
Marco Bo Hansen er læge og forsker i bakterier og infektionsbekæmpelse.
Han har en ph.d.-grad fra Københavns Universitet og Rigshospitalet, hvor han har forsket intenst i ”kødædende” bakterier.
Han har holdt adskillige foredrag og var en af de mest bookede oplægsholdere til Forskningens Døgn.
Derudover deltager han ofte i samfundsdebatter og TV-udsendelser, der omhandler kødædende bakterier, infektionsbekæmpelse og hygiejneadfærd.
Senest deltog han i DR dokumentarserie ”De Kødædende bakterier”, hvor der bl.a. var fokus på den meget tragiske sag om Nordjyskes chefredaktør, der mistede livet til de kødædende bakterier.
-calh













